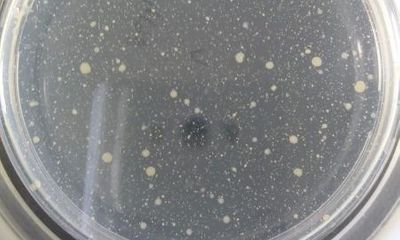
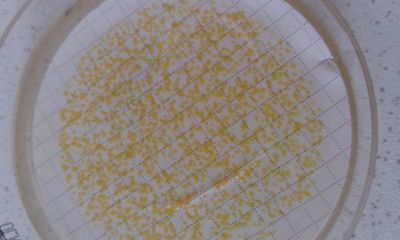

Co je dobré dodržovat při pití z lahve?

Pitný režim je nutné dodržovat, to jistě všichni víme. Důležité je pít tolik tekutin, abychom během dne nepociťovali velkou žízeň. A obzvlášť, pokud je velké teplo a více se potíme, tak bychom měli tělu dodávat hodně tekutin, aby horka lépe zvládalo. Jak si ale v průběhu dne zajistit dostatek tekutin, když třeba nemáme přístup k vodovodnímu kohoutku?
Naprostá většina lidí to řeší tím, že si nosí pití v lahvi, většinou plastové. To je samozřejmě dobrý způsob jak nežíznit, je ale důležité lahev dobře čistit a hlavně si často dotáčet čerstvou vodu. I voda se totiž může zkazit a my jsme se rozhodli zjistit, co se vlastně s vodou v lahvi během dne děje.
Co odhalily testy?
Požádali jsme laborantky Pražských vodovodů a kanalizací, aby nám udělaly test pitné vody a sledovaly její kvalitu poté, co se z lahve někdo napije. A výsledky nás docela překvapily.
Testovaly se 3 vzorky vody natočené do běžně používaných a dobře umytých plastových lahví:
1/ pitná voda natočená z vodovodního kohoutku,
2/ pitná voda z kohoutku obohacená o CO2 v přístroji Sodastream (perlivá voda),
3/ pitná voda s bezinkovým sirupem (voda se šťávou).
První testování proběhlo ihned po přípravě nápojů. V tu chvíli byla samozřejmě voda v té nejlepší kvalitě. Další testování proběhlo po 2,5 hodinách, během kterých lahve s vodou stály při pokojové teplotě a mezi tím se z nich laborantky několikrát napily. Druhé testování odhalilo, že se ve vodě začaly množit bakterie. Testy prokázaly, že už po tak krátké době jak je 2,5 hodiny se bakterie namnožily natolik, že jejich množství překročilo přísné limity pro pitnou vodu. Třetí test se konal po 5,5 hodinách a množství bakterií ve vodě bylo samozřejmě ještě mnohem větší.
Možná se ptáte, jak se bakterie do vody dostaly. Je to ale velmi snadné. Když se napijete, tak se obsah vašich úst, tedy část slin, dostane do lahve. Při pití přímo z lahve se tomu moc nedá zabránit. A díky pokojové teplotě se pak bakterie začnou velmi rychle množit.
Nemusíte se však bát, že by vás pití takové vody otrávilo. Jsou to bakterie, na které je vaše tělo zvyklé a umí si s nimi poradit. Kdybyste však vodu nechali stát v lahvi dlouho (třeba několik dní), mohou vám už přemnožené bakterie způsobit zdravotní komplikace jako je bolení břicha, průjem apod.
Co s tím?
A jak tedy množení bakterií zamezit? Ideální je nosit si spíš menší lahev, než velkou (přiměřené množství je cca 0,5 l) a když vodu vypijete, jednoduše si z vodovodního kohoutku natočíte vodu čerstvou. Před dotočením vody doporučujeme lahev vymýt nebo alespoň vypláchnout.
Důležité je také nechat vodu před natočením do lahve dostatečně odtéct. Vyzkoušejte rukou teplotu vody a teprve když je opravdu studená, napusťte ji do lahve. Teplá voda, která stála dlouho v trubkách, také není k pití vhodná.
A ještě jedna zajímavost na závěr. Laboratorními pokusy se zjistilo, že nejméně se kazil vzorek č. 3, tedy voda se šťávou. Cukr a kyseliny, které jsou v sirupech obsaženy, totiž působí jako konzervanty, které zpomalují množení bakterií.

PVK
PVK




